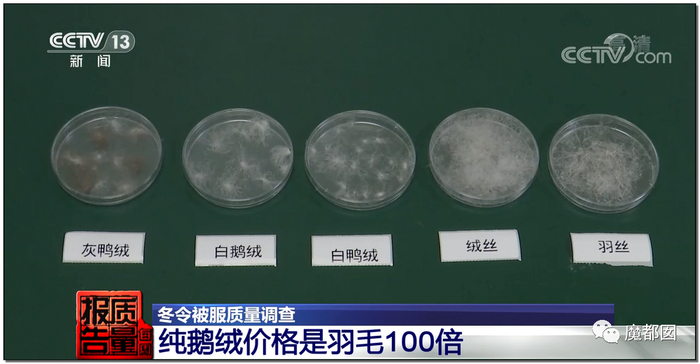

原标题:羽绒无绒、羊毛无毛!恒源祥、七匹狼、雪中飞等老牌国货被查! 来源:魔都囡
讲真,这事要不是央视爆出来我们真的没法去想象……甚至我们感觉非常的心痛……如果是什么垃圾牌子,小牌子搞这种事情也倒罢了,这可都是中国驰名几十年的老牌国货啊!!!怎么还能这样!!!
大家都知道现在外国对中国品牌都是虎视眈眈,动不动就来个“欲加之罪何患无辞”,恨不得把我们全部灭掉,此时此刻更需要我们国货当自强,顶住一片天,但是却出现这种事情,我们真的呆了半天,不知道说什么好……
这是央视报道的,不是地方小报报道的,绝对权威。报道的节目是最新一期,也就是3月28日刚刚播出的《每周质量报告》。

这次负责抽检的单位是这家:

抽检些什么项目呢?羽绒系列,比如羽绒服、羽绒被:

毛围巾:

棉服、冲锋衣:

还有一些羊绒衫等,基本上涵盖了冬季常用的衣服。




12.3%是什么概念?也就是外面9件衣服里就有一件衣服是不合格的……真的是……一塌糊涂……我们真心是难受,恨铁不成钢,别人现在在疯狂狙击我们的纺织品,我们自己却做成这个样子……
值得一提的是,这次抽检的很多电商品牌,除了某东某宝某品会某夕夕等,很多直播平台也纳入了考察,比如某音某手某红书等。

很多主播把自己的产品吹的天花乱坠:

事实上一塌糊涂:





羽绒被是直播平台抽检的重灾区。







电商平台尚且不行,直播平台问题更大,不合格率已经高于平均值:










直播平台三无产品特别多:

也就是说,如果把这些退货的三无产品算入,这个不合格率肯定就远远不止12.3%了,肯定是吓死人的数字。

大家要知道,12.3%是一个平均不合格率,细化到具体的项目里面就更夸张,围巾不合格达到了25%,外面4条围巾就有1条不合格,这是什么概念?简直胡闹……棉服是20%不合格,5件棉服就有1件不合格。

冬天最重要的羽绒服,大人小孩加起来不合格甚至超过了13%,按照比例,市场上7~8件羽绒服里就有一件是不合格的。

真的无语…从批次就能看出,羽绒服、羽绒被等是抽查重点。


羽绒被的抽查是南京和南通一起做的:


羽绒服的检测是常州和苏州、太仓一起做的,羽绒服成人80批次,儿童60批次:

羽绒服最常见的就是虚标,比如这件,标称134g:

而实际缺斤短两的厉害,只有90g:

可以看到,少了三分之一,根据国标,仅仅只允许5%的偏差:


羽绒服充绒量少还不算是严重,你们猜猜更严重的是什么?
Yes,给你填充的根本就不是羽绒!

国标中明确规定,羽绒服的填充物叫做朵绒:


因为只有带绒的才能堆积空气,形成保暖效果:


国标里不仅要求朵绒,而且对朵绒的占比也有要求:

而实际检测发现,很多羽绒服内根本就不是朵绒:

而是完全不带绒的那种羽丝:

这件儿童羽绒服,标称90%。猜猜最终是多少?
你想都不敢想!实际含绒量职业后3.3%!虚标30倍!



甚至严格来说,这种羽绒服根本不能算是羽绒服,顶多算是羽毛服,完全没有什么保暖效果。



更让我们痛心的是,最重要的儿童羽绒服竟然是重灾区!
这可是给孩子们穿的啊!怎么能这样搞法!你们良心何在???

央视例举了几个品牌,很多品牌好像还是热销货,比如这件优卡堤:

这是店铺宣传稿:

买到手是这样:

衣服标称是80%:

来来来,大家猜一下实际上是多少?
说出来吓死你们!实际含绒量竟然只有1.7%!!!

内部都是最便宜的那种羽毛丝:

甚至连苏州的这位检测员小姐姐都忍不住吐槽了,这是她从业以来检测过最差的羽绒服,实在太离谱了:


而成人羽绒服检测不合格里甚至出现了老牌国货,几十年历史的雪中飞品牌!雪中飞现在是波司登旗下,据中国商业联合会,中华商业信息中心对全国大型零售业商品销售统计显示:雪中飞羽绒服国内市场占有率已连续12年(2000-2011)行业第二,这样的品牌都会有问题?


这是雪中飞不合格的项目:

而在儿童羽绒服里,我们看到了一大批网红品牌:

而网上里买的羽绒被问题同样严重,比如这条,号称100%鹅绒:

是在一个快手的直播平台小店里买的:

实际呢?大家猜猜看,实际是多少?
3%?2%?1%?
错!实际是0%!一点鹅绒都没有!!

最重要的4项指标都不合格,羽绒含量、纤维、蓬松度等等,完全就是一劣质假货。

懂了吗?别说内里,甚至连面料都不合格,面料标称是100%全棉。

结果棉只有57%……




这位检测小姐姐也忍不住吐槽了,和前面那件羽绒服一样,这条所谓的羽绒被根本连羽绒被都算不上!


而这样的伪劣产品,赫然摆上了各种唬人的抬头:


更加骗人的就是看样:




甚至,检测人员在检测的过程中自己都出现了皮肤瘙痒的症状!可以想象这里面都是些什么货色,简直可怕!



根据检测中心的历史数据,这种电商产品现在问题极其严重:



而这条被子的成本价大概是多少?
说出来我们差点没跌倒……顶多就是100元左右,这么一条百元的劣质被再网红的直播里、在电商平台上活生生被炒到了近1000元,网友可能还觉得买到了便宜货……

假如按照这条被子的实际标称的品质来做,至少需要1500元,这还是成本价,我们可以想象,外面和网上那些几百元的羽绒被到底是个什么货色……

不同检验单位的专家都给出了相同的答案:只要是真鹅绒被就不可能便宜!鹅绒比鸭绒更好,价格当然更贵,绒朵要大很多,存储的空气就越多,保暖性能就越好。

大家可以看看不同羽绒之间的价格差距,羽丝和最贵的鹅绒差价可以达到10倍左右,最便宜的羽毛甚至可以差价到100倍!







这个利润差价是巨大的:
这几大类里面,问题最严重的就是围巾:

比如这条羊毛围巾,吊牌显示羊毛96%。

但是实测下来多少?大家猜猜……
或许你根本想不到,这条围巾上一根羊毛都没有!!!全部都是聚酯纤维!



这个只能用丧心病狂来形容了……

又如这条,号称羊毛和羊绒各占50%。

而实际上呢?这根大红的号称羊绒围巾的,一点点羊绒都没有,全部都是涤纶冒充。

大家猜猜这条如此无耻的羊绒围巾的品牌。
大家肯定猜不到,赫然就是中国驰名商标:七匹狼!!!

这条围巾还是从七匹狼的旗舰店购买的……

最讽刺的是店家竟然还提供了检测报告……其中花样百出,这份检测报告其实只是对一些耐汗渍这种进行了检测,产品本身的标准并无检测。








这是围巾不合格清单,我们很难想象,七匹狼这样的老牌国产名牌产品竟然也会搞这种事情……

而棉服同样问题严重,比如这件,标称100%的聚酯纤维:

但是实际检测出来是更便宜的锦纶……

换一件也是一样,标注有粘纤,实际上还是锦纶……

锦纶到底是个什么材料?
具体分析我们不展开,就说一句话大家就懂了,锦纶最多的是用来做袜子……没错,这些衣服都是用袜子的材料来做……

又比如这件,标注是比较好的氨纶:

但是实际检测依然是挂羊头卖狗肉,是比氨纶便宜的聚酯纤维:


而这些胡乱瞎标的品牌中我们赫然看到了恒源祥这种顶级国产顶级老牌!真的令人心痛!

除了这些老牌国货,还有一些著名时尚品牌,比如veromoda:

直播平台混乱不堪,现在很多老牌名牌企业也如此这般,我们的服装市场真的是让我们无语……现在的情况大家又不是不知道,外国这样搞法,我们还不争气,真的是没话说……不知道何时才能把这些伪劣产品彻底清除出中国市场……


